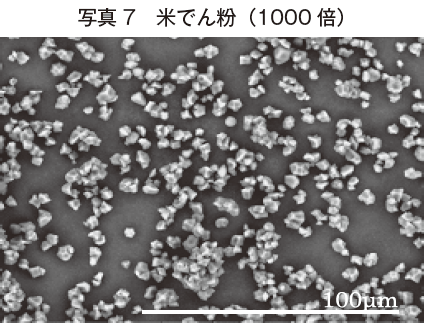

ホーム > でん粉 > でん粉のあれこれ > 食品加工素材としての各種でん粉
最終更新日:2012年5月10日
食品加工素材としての各種でん粉
2012年5月
東京都立食品技術センター 廣瀬 理恵子
はじめに
種々の植物の根や茎、種子に存在しているでん粉は重要な熱量源です。でん粉は冷水に溶けないため、植物組織を水などと共に磨砕、篩別、分級などの比較的単純な工程で分離することができることから、加工食品の物性改良など広い用途で利用されています。でん粉を工業的に生産している主な植物にはかんしょ、ばれいしょ、トウモロコシ、キャッサバ、サゴ、小麦、米などがありますが、由来する植物の種類によってでん粉粒子の大きさや形態は異なります。ここでは、植物組織に存在するでん粉粒子の形態と食品加工素材として分離したでん粉の利用についてご紹介させていただきます。
植物組織中のでん粉粒子の形態
植物組織中のでん粉の貯蔵状態を見るために、イモ類や穀類の断面を走査型電子顕微鏡で観察しました。
写真1はイモ類の細胞中に存在するでん粉粒の状態を示しました。かんしょは塊根中にでん粉を貯蔵しますが、複粒でん粉(1個のアミロプラスト*に複数のでん粉粒ができる)になっている状態が多く観察されました。一方、ばれいしょは塊茎にでん粉を貯蔵していますが、かんしょでん粉より大きく、単粒(1個のアミロプラストに1個のでん粉が形成される)で、丸味を帯びた粒子が多いことが観察されました。
*でん粉を蓄積する色素体
写真1はイモ類の細胞中に存在するでん粉粒の状態を示しました。かんしょは塊根中にでん粉を貯蔵しますが、複粒でん粉(1個のアミロプラスト*に複数のでん粉粒ができる)になっている状態が多く観察されました。一方、ばれいしょは塊茎にでん粉を貯蔵していますが、かんしょでん粉より大きく、単粒(1個のアミロプラストに1個のでん粉が形成される)で、丸味を帯びた粒子が多いことが観察されました。
*でん粉を蓄積する色素体

穀類については米と小麦の種子内にある胚乳組織の断面を観察して写真2に示しました。米の胚乳に蓄積されるでん粉粒は複粒で、各小粒子は隙間なく発達して数μm(1μm=1/1000ミリ)の微小な多角形になります(四角内に拡大)。小麦のでん粉粒には2種類のタイプがあり、第1次でん粉粒は胚乳細胞に最初に蓄積されるもので、レンズ形に生長した20〜40μmの大型粒子です。第1次でん粉粒の間隙に出現する第2次でん粉粒は10μmに満たない小粒子になります。

食品加工素材としての各種でん粉
でん粉を工業的に利用する際は植物組織から分離精製して用いられます。各種でん粉の写真と共に食品加工素材としての利用の一端をご紹介いたします。
かんしょでん粉は粘性が低くゲル化し易い性質から葛きりなど和菓子やハルサメに用いられますが、大半は糖化原料としての用途で利用されます。
一方、ばれいしょでん粉は糊化しやすく、そのゲルは透明で高い粘性があるので、かまぼこやソーセージなどの水畜産物の練製品の物性向上、ソースやたれの粘性やつや出しに利用されています。また、家庭用に用いられる片栗粉の原料としてもよく知られています。
日本のでん粉産業はこのばれいしょ、かんしょでん粉から発展しましたが、近年は原料が安価で安定供給されるトウモロコシから得られるコーンスターチが供給量の大半を占めています。
かんしょでん粉は粘性が低くゲル化し易い性質から葛きりなど和菓子やハルサメに用いられますが、大半は糖化原料としての用途で利用されます。
一方、ばれいしょでん粉は糊化しやすく、そのゲルは透明で高い粘性があるので、かまぼこやソーセージなどの水畜産物の練製品の物性向上、ソースやたれの粘性やつや出しに利用されています。また、家庭用に用いられる片栗粉の原料としてもよく知られています。
日本のでん粉産業はこのばれいしょ、かんしょでん粉から発展しましたが、近年は原料が安価で安定供給されるトウモロコシから得られるコーンスターチが供給量の大半を占めています。



コーンスターチは、従来から洋菓子などに用いられていましたが、現在は糖化用向けが多く、化工でん粉、ビールなどへの用途があります。
小麦でん粉は先に述べたとおり胚乳組織内では小粒子と大粒子が存在します。そこで、分級工程で沈降速度の差を利用した連続遠心離機により利用目的に応じた粒径のでん粉を分離します(小麦でん粉の写真6は分級をしていないものです)。
小麦でん粉は先に述べたとおり胚乳組織内では小粒子と大粒子が存在します。そこで、分級工程で沈降速度の差を利用した連続遠心離機により利用目的に応じた粒径のでん粉を分離します(小麦でん粉の写真6は分級をしていないものです)。

小麦でん粉は水畜産練製品に利用され、結着性などの品質向上、あるいは製菓でもビスケットのショートネス(ビスケットがさくさくすること)やスポンジケーキのボリュームアップなど品質向上の効果があります。
米でん粉は写真7で見られるように非常に微小です。皮膚や紙に付着しやすく凹凸面を平滑面に変える効果があるので、粉体の状態で化粧品や製紙などでの利用があるようです。
最近、小麦粉の替わりに米粉を用いて、パンや麺の製造が盛んです。しかし、でん粉の形態を見ただけでもこれだけの違いがあるので、糊化性、粘度などが異なる両者をただ単に置き換えだけでは同じような品質を持つ製品を作るのは難しいことです。
でん粉の持つ特性については様々な角度から多くの研究が進められ、大きな産業へと発展しましたが、食品加工への利用がさらに広がることに期待したいものです。
以上、食品の加工素材として利用されるでん粉について形態的な相違を中心に見ていただきました。
米でん粉は写真7で見られるように非常に微小です。皮膚や紙に付着しやすく凹凸面を平滑面に変える効果があるので、粉体の状態で化粧品や製紙などでの利用があるようです。
最近、小麦粉の替わりに米粉を用いて、パンや麺の製造が盛んです。しかし、でん粉の形態を見ただけでもこれだけの違いがあるので、糊化性、粘度などが異なる両者をただ単に置き換えだけでは同じような品質を持つ製品を作るのは難しいことです。
でん粉の持つ特性については様々な角度から多くの研究が進められ、大きな産業へと発展しましたが、食品加工への利用がさらに広がることに期待したいものです。
以上、食品の加工素材として利用されるでん粉について形態的な相違を中心に見ていただきました。
参考文献
不破英次、小巻利章、檜作進、貝沼圭二(編):澱粉科学の事典、朝倉書店(2003)
星川清親:食用作物、養賢堂(1992)
全国小麦粉分離加工協会:小麦でん粉及び小麦たん白(改訂版)
星川清親:食用作物、養賢堂(1992)
全国小麦粉分離加工協会:小麦でん粉及び小麦たん白(改訂版)
このページに掲載されている情報の発信元
農畜産業振興機構 調査情報部 (担当:企画情報グループ)
Tel:03-3583-8678
農畜産業振興機構 調査情報部 (担当:企画情報グループ)
Tel:03-3583-8678










